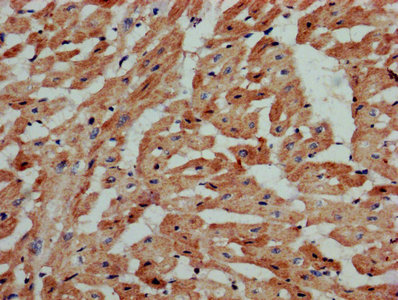

-
中文名稱:S1PR3兔多克隆抗體
-
貨號:CSB-PA859932LA01HU
-
規(guī)格:¥440
-
圖片:
-
IHC image of CSB-PA859932LA01HU diluted at 1:800 and staining in paraffin-embedded human kidney tissue performed on a Leica BondTM system. After dewaxing and hydration, antigen retrieval was mediated by high pressure in a citrate buffer (pH 6.0). Section was blocked with 10% normal goat serum 30min at RT. Then primary antibody (1% BSA) was incubated at 4°C overnight. The primary is detected by a biotinylated secondary antibody and visualized using an HRP conjugated SP system.
-
IHC image of CSB-PA859932LA01HU diluted at 1:800 and staining in paraffin-embedded human heart tissue performed on a Leica BondTM system. After dewaxing and hydration, antigen retrieval was mediated by high pressure in a citrate buffer (pH 6.0). Section was blocked with 10% normal goat serum 30min at RT. Then primary antibody (1% BSA) was incubated at 4°C overnight. The primary is detected by a biotinylated secondary antibody and visualized using an HRP conjugated SP system.
-
Immunofluorescent analysis of MCF-7 cells using CSB-PA859932LA01HU at dilution of 1:100 and Alexa Fluor 488-congugated AffiniPure Goat Anti-Rabbit IgG(H+L)
-
-
其他:
產品詳情
-
產品名稱:Rabbit anti-Homo sapiens (Human) S1PR3 Polyclonal antibody
-
Uniprot No.:
-
基因名:
-
別名:S1PR3; EDG3; Sphingosine 1-phosphate receptor 3; S1P receptor 3; S1P3; Endothelial differentiation G-protein coupled receptor 3; Sphingosine 1-phosphate receptor Edg-3; S1P receptor Edg-3
-
宿主:Rabbit
-
反應種屬:Human
-
免疫原:Recombinant Human Sphingosine 1-phosphate receptor 3 protein (303-378AA)
-
免疫原種屬:Homo sapiens (Human)
-
標記方式:Non-conjugated
本頁面中的產品,S1PR3 Antibody (CSB-PA859932LA01HU),的標記方式是Non-conjugated。對于S1PR3 Antibody,我們還提供其他標記。見下表:
-
克隆類型:Polyclonal
-
抗體亞型:IgG
-
純化方式:>95%, Protein G purified
-
濃度:It differs from different batches. Please contact us to confirm it.
-
保存緩沖液:Preservative: 0.03% Proclin 300
Constituents: 50% Glycerol, 0.01M PBS, PH 7.4 -
產品提供形式:Liquid
-
應用范圍:ELISA, IHC, IF
-
推薦稀釋比:
Application Recommended Dilution IHC 1:500-1:1000 IF 1:50-1:500 -
Protocols:
-
儲存條件:Upon receipt, store at -20°C or -80°C. Avoid repeated freeze.
-
貨期:Basically, we can dispatch the products out in 1-3 working days after receiving your orders. Delivery time maybe differs from different purchasing way or location, please kindly consult your local distributors for specific delivery time.
-
用途:For Research Use Only. Not for use in diagnostic or therapeutic procedures.
相關產品
靶點詳情
-
功能:Receptor for the lysosphingolipid sphingosine 1-phosphate (S1P). S1P is a bioactive lysophospholipid that elicits diverse physiological effect on most types of cells and tissues. When expressed in rat HTC4 hepatoma cells, is capable of mediating S1P-induced cell proliferation and suppression of apoptosis.
-
基因功能參考文獻:
- Reactive astrocytic S1P3 signaling modulates the blood-tumor barrier in brain metastases. PMID: 30006619
- Authors found that elevated levels of pSphK1 were positive correlation with high expression of S1P, which in turn promoted metastasis of TNBC through S1P/S1PR3/Notch signaling pathway. PMID: 29605826
- Sphingosine-1-phosphate receptor 3 (S1PR3) mediates multiple aspects of the inflammatory response during sepsis. PMID: 28850247
- in breast cancer cells overexpression of S1P3 and its activation by S1P has pro-inflammatory and pro-metastatic potential by inducing COX-2 expression and PGE2 signaling via EP2 and EP4. PMID: 27616330
- High S1PR3 expression is associated with increased lung adenocarcinoma. PMID: 27856637
- The study shows that S1P receptor 3 (S1PR3) mRNA is overexpressed in EBV-positive NPC patient-derived xenografts and a subset of primary NPC tissues, and that knockdown of S1PR3 suppressed the activation of AKT and the S1P-induced migration of NPC cells. PMID: 28240350
- S1pr3 promotes leukocyte rolling by mobilization of endothelial P-selectin. PMID: 25832730
- Stimulation with sphingosine-1-phosphate enhances cancer stem cells via S1PR3 and subsequent Notch1 activation. PMID: 25254944
- TRPC1 functions as a major regulator of S1P3 and VEGFR2 expression. PMID: 25971967
- Data indicate that sphingosine 1-phosphate (S1P) and hepatocyte growth factor (HGF) induced transloaction of integrin beta4, S1P receptors S1PR2 and S1PR3 to endothelial cell membrane caveolin-enriched microdomains (CEMs). PMID: 24851274
- a novel signaling axis, i.e., ROCK-JNK-ETS-1-CD44 pathway, which plays an essential role in the S1P3-regulated chemotactic response. PMID: 24064218
- associations were found for 2 promoter SNPs across 2 European descent samples supporting association of alleles -1899G and -1785C with decreased risk for sepsis-associated acute respiratory distress syndrome (ARDS); alleles reduced transcription factor binding to S1PR3 promoter and S1PR3 promoter activity; associated with lower plasma S1PR3 protein in ARDS patients PMID: 23911438
- Sphingosine 1-phosphate receptor 3 regulates recruitment of anti-inflammatory monocytes to microvessels during implant arteriogenesis. PMID: 23918395
- S1PR agonists are pro-fibrotic via S1P2R and S1P3R stimulation using Smad-independent pathways. PMID: 23589284
- S1P3 receptors are detected in virtually all neurons in dorsal root ganglion and mediate pain behavior. PMID: 23392686
- Inhibition of S1P3 receptors prevented E2-induced activation of Cdc42, supporting the important role of the S1P receptor in E2 signaling. PMID: 23142484
- S1PR3 is nitrated on specific tyrosine residues and released as endothelial cell microparticles during acute lung injury. PMID: 22771388
- Suggest that the enhanced S1P3-EGFR signaling axis may contribute to the tumorigenesis or progression of lung adenocarcinomas. PMID: 22344462
- S1PR3 was higher in iliac-femoral arteries compared with carotid arteries. PMID: 22308044
- S1P regulates MMP-9 induction and invasiveness through coupling of S1P3 and G(alphaq) in MCF10A cells, thus providing a molecular basis for the crucial role of S1P in promoting breast cell invasion. PMID: 21652634
- These results suggest a potential role for HDL and S1P receptors in the pathogenesis of prostate cancer. PMID: 20979115
- The follicular fluid-HDL-associated S1P promotes granulosa lutein cell migration via S1PR3 and RAC1 activation. This may represent a novel mechanism contributing to the development of the corpus luteum. PMID: 20980685
- amplification of SHC3 and EDG3 genes suggests that the two proteins co-operate and are important for ependymomas in vivo. PMID: 19748727
- a 9-amino acid peptide (KRX-725), derived from the second intracellular loop of S1P3 (EDG3) mimics sphingosine 1-phosphate (S1P) by triggering a Gi-dependent mitogen-activated protein kinase kinase and extracellular signal-regulated kinase signal. PMID: 12763936
- S1P(3) function is not subject to conventional regulation by GRK phosphorylation PMID: 15894172
- Expression of the sphingosine 1 phosphate receptor in primary endothelial cells is both sufficient and necessary for the expression of Akt3. PMID: 16527273
- Reults describe the role of mu opioid receptors and S1P3 transactivation in the attenuation of vascular permeability by methylnaltrexone. PMID: 17395891
- Cytosolic phospholipase A2alpha activation induced by S1P is mediated by the S1P3 receptor in lung epithelial cells.( PMID: 18502815
- Results suggest that S1PR3 is involved in COX2 dependent effects of high-density lipoprotein on vascular smooth muscle. PMID: 18612546
- Report different response patterns of several ligands at the sphingosine-1-phosphate receptor subtype 3 (S1P(3)). PMID: 19309361
顯示更多
收起更多
-
亞細胞定位:Cell membrane; Multi-pass membrane protein.
-
蛋白家族:G-protein coupled receptor 1 family
-
組織特異性:Expressed in all tissues, but most abundantly in heart, placenta, kidney, and liver.
-
數據庫鏈接:
Most popular with customers
-
YWHAB Recombinant Monoclonal Antibody
Applications: ELISA, WB, IHC, IF, FC
Species Reactivity: Human, Mouse, Rat
-
Phospho-YAP1 (S127) Recombinant Monoclonal Antibody
Applications: ELISA, WB, IHC
Species Reactivity: Human
-
-
-
-
-
-